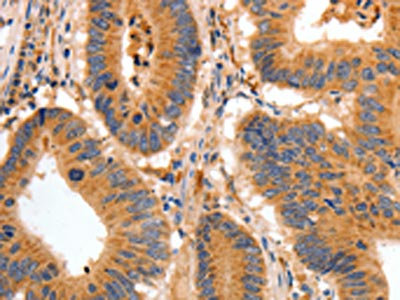

BAIAP2 Antibody
-
中文名稱:BAIAP2兔多克隆抗體
-
貨號:CSB-PA585175
-
規格:¥1100
-
圖片:
-
The image on the left is immunohistochemistry of paraffin-embedded Human colon cancer tissue using CSB-PA585175(BAIAP2 Antibody) at dilution 1/30, on the right is treated with fusion protein. (Original magnification: ×200)
-
Gel: 8%SDS-PAGE, Lysate: 40 μg, Lane: SKOV3 cells, Primary antibody: CSB-PA585175(BAIAP2 Antibody) at dilution 1/350, Secondary antibody: Goat anti rabbit IgG at 1/8000 dilution, Exposure time: 40 seconds
-
-
其他:
產品詳情
-
Uniprot No.:
-
基因名:
-
別名:BAI-associated protein 2 antibody; BAI1 associated protein 2 antibody; BAI1-associated protein 2 antibody; BAIAP 2 antibody; Baiap2 antibody; BAIP2_HUMAN antibody; BAP2 antibody; Brain-specific angiogenesis inhibitor 1-associated protein 2 antibody; Fas ligand-associated factor 3 antibody; FLAF3 antibody; Insulin receptor substrate p53 antibody; Insulin receptor substrate p53/p58 antibody; Insulin receptor substrate protein of 53 kDa antibody; IRS-58 antibody; IRSp53 antibody; IRSp53/58 antibody; Protein BAP2 antibody
-
宿主:Rabbit
-
反應種屬:Human,Mouse,Rat
-
免疫原:Fusion protein of Human BAIAP2
-
免疫原種屬:Homo sapiens (Human)
-
標記方式:Non-conjugated
-
抗體亞型:IgG
-
純化方式:Antigen affinity purification
-
濃度:It differs from different batches. Please contact us to confirm it.
-
保存緩沖液:-20°C, pH7.4 PBS, 0.05% NaN3, 40% Glycerol
-
產品提供形式:Liquid
-
應用范圍:ELISA,WB,IHC
-
推薦稀釋比:
Application Recommended Dilution ELISA 1:1000-1:5000 WB 1:200-1:1000 IHC 1:50-1:200 -
Protocols:
-
儲存條件:Upon receipt, store at -20°C or -80°C. Avoid repeated freeze.
-
貨期:Basically, we can dispatch the products out in 1-3 working days after receiving your orders. Delivery time maybe differs from different purchasing way or location, please kindly consult your local distributors for specific delivery time.
-
用途:For Research Use Only. Not for use in diagnostic or therapeutic procedures.
相關產品
靶點詳情
-
功能:Adapter protein that links membrane-bound small G-proteins to cytoplasmic effector proteins. Necessary for CDC42-mediated reorganization of the actin cytoskeleton and for RAC1-mediated membrane ruffling. Involved in the regulation of the actin cytoskeleton by WASF family members and the Arp2/3 complex. Plays a role in neurite growth. Acts syngeristically with ENAH to promote filipodia formation. Plays a role in the reorganization of the actin cytoskeleton in response to bacterial infection. Participates in actin bundling when associated with EPS8, promoting filopodial protrusions.
-
基因功能參考文獻:
- Coincident with the loss of PICK1 by GBF1-activated ARF1, CDC42 recruitment leads to the activation of IRSp53 and the ARP2/3 complex, resulting in a burst of F-actin polymerisation potentially powering scission. PMID: 29743604
- A BAIAP2 polymorphism, rs8079626, affects medial frontal gyrus and inferior parietal lobe connectivity in attention deficit hyperactivity order adults. PMID: 28938222
- BAIAP2 is a candidate gene for mediating dendritic spine density abnormalities in schizophrenia. Data suggest that altered DNA methylation in schizophrenia may be a mechanism for schizophrenia-related dendritic spine density reductions. PMID: 28195572
- Overexpression of LIN7 or IRSp53 did not prevent the formation of hyperfused mitochondria in cells coexpressing the Drp1 K38A mutant, thus suggesting that LIN7-IRSp53 complex requires functional Drp1 to regulate mitochondrial morphology. PMID: 27320196
- Results suggest the hypothesis that defective actin/membrane modulation in IRSp53-deficient dendritic spines may lead to social and cognitive deficits through N-methyl-d-aspartate receptor dysfunction. PMID: 26275848
- dimers sense negative membrane curvature, display a non-monotonic sorting with curvature, and expand the membrane tube at high imposed tension while constricting it at low tension PMID: 26469246
- determined the alpha-synuclein-binding domain of beta-III tubulin and demonstrated that a short fragment containing this domain can suppress alpha-synuclein accumulation in the primary cultured cells PMID: 25031323
- BAIAP2 is related to emotional modulation of human memory strength. PMID: 24392092
- These above results indicated the possible involvement of BAIAP2 in the etiology of attention deficit disorder with hyperactivity, especially ADHD-I. PMID: 24377651
- IRSp53 adopts a closed inactive conformation that opens synergistically with the binding of human Cdc42 to the CRIB-PR and effector proteins, such as the tumor-promoting factor Eps8, to the SH3 domain. PMID: 24584464
- LIN7 is a novel regulator of IRSp53. PMID: 22767515
- mDia1 and WAVE2 are important Src homology 3 domain partners of IRSp53 in forming filopodia. PMID: 22179776
- Structural basis for complex formation between human IRSp53 and the translocated intimin receptor Tir of enterohemorrhagic E. coli PMID: 21893288
- Studied generation of filopodia with regards to the dynamic interaction established by Eps8, IRSp53 and VASP with actin filaments. PMID: 21814501
- A molecular dynamics study of the interaction between domain I-BAR of the IRSp53 protein and negatively charged membranes PMID: 21542353
- The results of this study and the supporting evidence highlighted previously suggest that the BAIAP2 gene may be involved in autism susceptibility. PMID: 20888579
- Suppression of IRSp53 expression inhibited IGF-I-induced membrane targeting and local accumulation of WAVE2 at the leading edge of cells. PMID: 20621182
- Cdc42 regulates the activity of IRSp53 by regulating the IRSp53-WIRE interaction as well as localization of the complex to plasma membrane to generate filopodia. PMID: 20678498
- IRSp53, through its interaction with Eps8, not only affects cell migration but also dictates cellular growth in cancer cells. PMID: 20418908
- IRSp53 and spinophilin regulate localized Rac activation by T-lymphocyte invasion and metastasis protein 1 PMID: 20360004
- this work does not conform to current views that the inverse-BAR domain or Cdc42 controls IRSp53 localization but provides an alternative model of how IRSp53 is recruited (and released) to carry out its functions at lamellipodia and filopodia. PMID: 19933840
- LIN7B is a partner of IRSp53 anchoring the actin-based membrane cytoskeleton at cell-cell contacts. PMID: 14596909
- IRSp53, when activated by small GTPases, participates in F-actin reorganization not only in an SH3-dependent manner but also in a manner dependent on the activity of the IRSp53/MIM homology domain PMID: 14752106
- IRSp53 comprises a central SH3 domain, which binds to proline-rich regions of a wide range of actin regulators, and a conserved N-terminal IRSp53/MIM homology domain that harbours F-actin-bundling activity. Presents crystal structure of this novel domain PMID: 15635447
- These results suggest that PSD-95 interaction is an important determinant of synaptic IRSp53 localization and that the SH3 domain of IRSp53 links activated Rac1/Cdc42 to downstream effectors for the regulation of spine morphogenesis. PMID: 15673667
- The mechanism of membrane deforamtion induced by the IRSp53 RCB domain is reported. PMID: 17003044
- These results support a model whereby the synergic bundling activity of the IRSp53-Eps8 complex, regulated by Cdc42, contributes to the generation of actin bundles, thus promoting filopodial protrusions. PMID: 17115031
- Together, these data reveal that interplay between actin dynamics and a novel membrane-deformation activity promotes cell motility and morphogenesis. PMID: 17371834
- tyrosine 310 as a primary site of tyrosine phosphorylation in response to insulin signalling and we have shown that although IRSp53 is tyrosine phosphorylated in response to epidermal growth factor receptor signalling, tyrosine 310 is not crucial. PMID: 18417251
- LIN7-IRSp53 association plays a role during assembly of functional tight junctions and surface polarization in epithelial cells PMID: 19054385
- Both spatial learning and novel object recognition are impaired in transgenic mice deficient of IRSp53 expression. PMID: 19193906
- The authors show that IRSp53 family members, key regulators of membrane and actin dynamics, directly interact with both Tir and EspF(U).[Tir & EspFU] PMID: 19286134
- SPIN90 and IRSp53 positively cooperated to mediate Rac activation, and co-expression of SPIN90 and IRSp53 in COS-7 cells led to the complex formation of SPIN90-IRSp53 in the leading edge of cells PMID: 19460367
- this study support the participation of BAIAP2 in the continuity of ADHD across life span,in some of the populations analyzed, suggest that genetic factors potentially influencing abnormal cerebral lateralization may be involved in this disorder. PMID: 19733838
- The authors demonstrated that the association between the enterohemorrhagic Escherichia coli O157:H7 EspFu and IRSp53 induces dynamic membrane remodeling in epithelial cells. PMID: 19762983
顯示更多
收起更多
-
亞細胞定位:Cytoplasm. Membrane; Peripheral membrane protein. Cell projection, filopodium. Cell projection, ruffle. Cytoplasm, cytoskeleton. Note=Detected throughout the cytoplasm in the absence of specific binding partners. Detected in filopodia and close to membrane ruffles. Recruited to actin pedestals that are formed upon infection by bacteria at bacterial attachment sites.
-
組織特異性:Isoform 1 and isoform 4 are expressed almost exclusively in brain. Isoform 4 is barely detectable in placenta, prostate and testis. A short isoform is ubiquitous, with the highest expression in liver, prostate, testis and placenta.
-
數據庫鏈接:
Most popular with customers
-
-
YWHAB Recombinant Monoclonal Antibody
Applications: ELISA, WB, IHC, IF, FC
Species Reactivity: Human, Mouse, Rat
-
Phospho-YAP1 (S127) Recombinant Monoclonal Antibody
Applications: ELISA, WB, IHC
Species Reactivity: Human
-
-
-
-
-